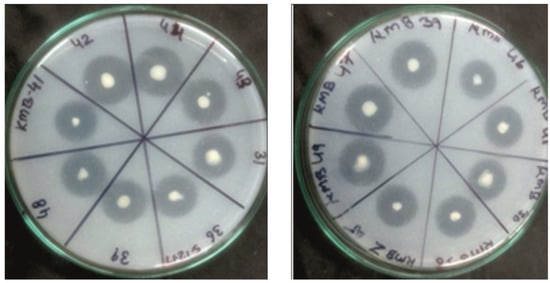

Abstract
Potassium (K) helps crop plants to resist biotic and abiotic challenges and plays a vital role in biochemical, metabolic, and physiological processes. Due to intense agricultural practices over the past few decades, the soil K reserve has been observed to be decreasing globally. It is possible to view potassium-solubilizing bacteria (KSB), which uses a number of biological mechanisms to convert potassium from inaccessible forms and make it accessible to crop plants, as a viable method for managing K in soils with low potassium levels. The present study encompasses 44 KSB strains isolated from rhizospheric soils collected from southern Rajasthan, India and characterized based on morphological, biochemical, and molecular profiles. All the isolates exhibited potassium solubilization and were identified using ERIC, BOX, REP PCR, and 16 S rDNA amplification which exhibited significant diversity amongst the strains. A flame-photometric analysis revealed that significant amounts of potassium were released by isolates from muscovite mica on the 21st day of incubation. These KSB strains produced hydrolytic enzymes and plant growth-promoting activities at different environmental stresses. In comparison to the absolute control (control without KSB), maize seedlings grown from bacterized seeds showed an increase in shoot length, root length, leaf number, total chlorophyll content, and the expression of stress-related enzymes. These native strains, which have a variety of advantageous traits, may be able to replace synthetic K fertilizers in order to increase food production while reducing pollution and restoring degraded land for agricultural use.
1. Introduction
Potassium (K), known as the “quality nutrient”, is the third most important essential macronutrient after nitrogen and phosphorus for crop yield and quality and has significant biological functions in sustaining the growth, development, and grain/seed quality of plants [1]. Its deficiency leads to poorly developed root systems, slow plant growth, small seed size, and poor crop yields. K not only has a role in the synthesis of cell and other biological macro-molecules, i.e., proteins and enzymes, carbohydrates (starch and cellulose), and vitamins but also contributes to nutrient uptake and transportation, and ultimately alleviates biotic and abiotic stresses, thereby contributing to enhanced quality production in crops [2].
Potassium accounts for approximately 2.5 percent of the lithosphere, in which the nutrient content ranges from 0.04 to 3.0 percent in the soil [3]. In soil, K primarily exists in four distinct forms: as a mineral, non-exchangeable, exchangeable, and soluble, i.e., cations (K+) which are absorbed by plant roots [4]. K minerals are present in a fixed form which is solubilized/mineralized by potassium solubilizers, and then absorbed and assimilated by plant roots [3]. The soil K content for normal agricultural soils ranges from 2 to 5 mg L–1 and comprises of approximately 1–10% of the non-exchangeable source trapped explicitly between the layers or sheets of distinct types of clay minerals [5]. Owing to inadequate fertilizer use, significant increase in crop yield (depleting soil solution K), and depletion of K in the soil system, large quantities of K in the soil occur in a fixed form (non-available to plants indirectly) [6,7]. The rapid K depletion of the soil by high-yielding cultivars in intensive crop cultivation systems, coupled with the lack of effective K replacement protocols has induced an escalating K deficiency in soils due to the imbalanced application of fertilizers [8,9].
In certain types of soil, the available K content ranges below the minimum requirements, rendering K fertilizers a necessity for sustainable crop production [10,11]. The addition of crop residue, which contains a significant amount of K, to the soil was not practiced by farmers, thus worsening the K depletion status across the soil [12,13]. As a crucial nutrient, rising demands for K for agricultural crop growth may spur global K fertilizer output in response to rising synthetic fertilizer demand [14]. An alternate indigenous supply of K is desirable for optimum plant uptake in order to combat these constraints and retain the K status available in the soils to support crop production [15,16]. In this context, efficient PGP microbes such as Pseudomonas, Acidothiobacillus, Bacillus spp., and Paenibacillus, etc., with potassium-solubilizing abilities may act as an alternative but viable technology to make K freely available to plants [17]. The mechanism of microbial potassium solubilization is mainly attributed to the excretion of organic acids, which directly dissolve either rock K or chelate silicon ions to bring K into the solution and thus lower the pH, helping in K mineral mobilization and uptake by plants [18].
Thus, the identification of microbial strains capable of mobilizing K minerals quickly with higher efficacy and PGPR activities can conserve our existing resources and restore the productivity of degraded, marginally productive, and unproductive agricultural soils; conditions caused by the heavy application of chemical fertilizers. Keeping all these points in consideration, the focus of the present investigation is to assess the genetic diversity of efficient and competent indigenous potassium-solubilizing bacteria isolated from the southern regions of Rajasthan and to study their efficacy by the application of these microbial strains as a biocontrol agent to improve the productivity potential of maize (Zea mays L.).
2. Materials and Methods
2.1. Sample Site and Collection
The rhizospheric soil samples, from up to 10 cm depth, were collected from various field crops (maize and wheat) located in various geographical domains of southern Rajasthan such as Udaipur (24.5568° N, 73.7153° E), Rajsamand (25.2235° N, 73.7478° E), Bhilwara (25.3407° N, 74.6313° E), Banswara (23.5461° N, 74.4350° E), Chittorgarh (24.8829° N, 74.6230° E), Dungarpur (23.8417°N, 73.7147° E), and Pratapgarh (24.0317° N, 74.7787° E). The samples were individually sealed in sterilized ziplock poly bags, labelled, and transported to the laboratory [19].
2.2. Isolation of KSB and Media Optimization
A total of eighty different strains were isolated and purified using a standard serial dilution protocol from the soil samples of various crop plants on modified Aleksandrov agar media plates supplemented with mica (sole source of potassium) and incubated overnight for 7 days at 28 ± 2 °C for the screening of potassium-solubilizing bacteria [20]. After seven days, sixty-five morphologically distinct colonies exhibiting a transparent halo zone were selected and considered as potassium-solubilizing bacteria. All the sixty-five bacterial isolates were screened and optimized at different conditions such as culture media, temperature, and pH, an efficient forty-four strains producing a prominent halo zone around them were selected and were further spot tested [21]. These colonies were subjected to repeated subculturing in order to attain a single pure colony and purified using the streak plate method for further studies. The glycerol stocks (20%) were prepared and stored immediately in labeled vials at −50 °C deep freezer (Thermo Scientific™, Leicestershire, UK).
2.3. Qualitative (Plate Assay) and Quantitative (Broth Assay) Estimation of Potassium-Solubilizing Potential of the Isolates
The potential of potent KSB isolates to solubilize insoluble potassium was assessed both by in vitro plate assay (qualitative) and in vivo broth assay (quantitative). In order to evaluate the potassium-solubilizing ability, the strains were placed on Aleksandrov agar media and the plates were incubated at 28 ± 2 °C for 5–7 days [22]. The diameter of the bacterial colonies and halozones were measured and the values were used to calculate the solubilization index by following the formula [23]:
SI = [Colony diameter + Halozone diameter]/Colony diameter
A quantitative estimation of potassium solubilization by the bacterial cultures was determined using flame photometry. To the 100 mL of sterilized Aleksandrov broth bearing mica as a mineral potassium source in a 250 mL Erlenmeyer flask, 1% of bacterial suspension were inoculated and incubated at 28 ± 2 °C for 10 days [24]. For each isolate, three flasks were inoculated on rotary shaker (150 rpm) at 30 ± 2 °C and after 7, 14, and 21 days, each flask was checked for potassium release by flame photometry as per the method outlined by [25].
2.4. Morphological and Biochemical Characterization of KSB
Bacterial smears of all the isolated KSB strains were gram stained and morphological characterization was done using a light microscope based on colony morphology [22,26]. For preliminary characterization of the potassium-solubilizing strains, the following biochemical tests were performed: oxidase [27], catalase [28], citrate utilization [29], methyl red (MR), Voges–Proskauer (VP), urease [30], and gelatin-liquefaction test [31], following the standard procedures.
2.5. Molecular Identification of KSB
The genomic DNA from the KSB isolates and amplified ribosomal DNA (rDNA) restriction analysis (ARDRA) based molecular characterization were performed by the method outlined by Jain et al. (2017) [32]. Amplification of 16S rDNA region and the 16S rDNA amplicons were digested using different restriction endonucleases [33]. Molecular characterization of KSB strains was also performed by PCR amplification of BOX, ERIC, and REP repetitive elements fingerprinting [34]. Data analysis was done using NTSYS-PC (Numerical Taxonomy and Multivariate Analysis System) software Version 2.2 [35].
2.6. Screening for Multiple Plant Growth-Promoting Activities, Abiotic Stress Tolerance, and Hydrolytic Activities of Potent KSB Strains
All the KSB strains were further assessed for multiple plant growth-promoting activities, viz., IAA production, GA3 production, HCN production, ACC deaminase activity, siderophore production, ammonia production, silica solubilization, zinc solubilization, antagonistic activity, qualitative and quantitative estimation of exopolysaccharides, biofilm production, and phosphate solubilization according to the standard methodologies [36]. The KSB isolates were also tested for hydrolytic enzyme production such as phytase, lipase, amylase, protease, cellulase, chitinase, and different abiotic stress tolerance attributes, viz., pH tolerance, temperature tolerance, salinity tolerance, drought tolerance, and antibiotic sensitivity were evaluated [26,37].
2.7. In Vitro Studies on the Effect of Potassium-Solubilising Bacteria on Growth of Maize Seedlings
The pot experiment was laid out in a completely randomized design (CRD) with 3 replicates per treatment [34]. The seeds of maize were sterilized by using 1% (w/v) sodium hypchlorite for three minutes and washed with 60% alcohol. The sterilized maize (FEM-2) seeds were treated with KSB and placed in pots containing an autoclaved mixture of vermiculite, perlite, and cocopeat and placed inside the plant growth chamber (humidity: 60%, light intensity: 750 μmol/m2s with 15 h light and 9 h dark conditions at 25–20 °C). The pots were irrigated every 7 days with distilled water and Hoagland’s solution. After 30 days, different plant growth parameters like average shoot length, root length, leaf number, chlorophyll content of leaf number, and stress related enzymes, viz., CAT, SOD, POD, PPO, and PAL were analyzed.
2.8. Sequencing and Phylogenetic Analysis of 16S rDNA of Potent KSB Strains
The PCR-amplified 16S rDNA region of potent KSB was sequenced using an automated DNA sequencer (ABI model 377, Applied Biosystems, Foster City, CA, USA) and analyzed as per our previously published research and the accession numbers of the 16S rDNA were also obtained by submitting the DNA sequence at NCBI [36].
2.9. Statistical Analysis
All the data were recorded in triplicate and the standard deviation was calculated using Microsoft Excel. Pot data analysis was analyzed using the analysis of variance determining levels of significance using standard procedure as outlined by Panse and Sukhatme (1989). The significant difference was calculated at 5% significance level.
3. Results and Discussions
3.1. Isolation and Screening of Potassium-Solubilizing Bacterial Isolates
Eighty strains were isolated and purified from soil samples of various crops on modified Aleksandrov agar media plates supplemented with mica (sole source of potassium) and incubated at 28 ± 2 °C for the screening of potassium-solubilizing bacteria. After seven days, distinct colonies exhibiting a transparent halo zone were observed in sixty-five strains and considered as potassium-solubilizing bacteria. All the sixty-five bacterial isolates were screened and optimized at different conditions such as culture media, temperature, and pH, forty-four strains producing a prominent halo zone around them were selected, which were further spot tested (Figure 1). These colonies were subjected to repeated subculturing in order to attain a single pure colony and were purified using the streak plate method for further studies. Similar findings for the isolation, screening, and optimization of the KSB strains stated in this study were also thoroughly documented by Dong et al. [38], by whom a total of 149 isolates capable of potassium release were identified, out of a total of 1678 isolated bacteria. After five days of incubation, fast-growing and slimy colonies exhibiting a translucent zone were considered as KSB.
Figure 1.
Zone of solubilization of KSB isolates on Aleksandrov medium.
3.2. Qualitative (Plate Assay) and Quantitative (Broth Assay) Estimation of Potassium-Solubilizing Potential of the Isolates
The K-solubilizing potential of the potent KSB isolates was anticipated by evaluating the formation of large clear/halo zones around the bacterial colonies on Aleksandrov agar media plates. All the isolates exhibited efficient K solubilization. Maximum KSI was observed by KSB 13 (6.70 ± 0.10) followed by KSB 38 (6.20 ± 0.10), KSB 44 (6.10 ± 0.10), and KSB 41 (6.00 ± 0.10). The minimum was observed in the case of KSB 25 (2.00 ± 0.10) (Table 1). The results of the present study were found to be in accordance with the earlier studies reported by Parmar et al. (2016) [22]. Out of the twenty-five isolates, five bacterial isolates KSB-1 (5.20), KSB-3 (5.00), KSB-9 (4.60), KSB-17 (4.56), and KSB-20 (3.78) exhibited a higher solubilization index for potassium solubilization.

Table 1.
Solubilization index and in vitro solubilization assay of isolated KSB.
The isolates exhibiting the zone of solubilization on Aleksandrov agar medium were further evaluated for their ability to release K in broth media. The flame photometric analysis deciphered the amount of K released from muscovite mica in the broth by the isolates at 7, 14, and 21 days after incubation in lab conditions and were documented in the range of 28.5 to 96.1 μg/mL (Table 1). Gore et al. (2019) [39] reported that among the 32 isolates, KSB 49 released the maximum amount of potassium from mica (239.75 mgL−1) followed by KSB 43 (228.25 mgL−1), and KSB 47 (205.75 mgL−1) and were considerably superior over all other isolates.
3.3. Morphological and Biochemical Characterization of KSB Isolates
The screened isolates were subjected to morphological characterization for their presumptive identification, as earlier described [39]. The culture characteristics including color, appearance, Gram reaction, shape, margin, form, and elevation of the isolates on the plate media were studied. Based on Gram’s reaction and the KOH test, all the 44 isolates were found to be Gram-negative rods and cocci (Supplementary Sheet Table S1). Similarly, Fatharani et al. [40] reported the morphological colony (shape, margin, elevation, surface, pigmentation, and optic) and cell morphology of seven bacterial isolates. Among these, five were Gram positive and two were found to be Gram negative with either cocci or bacilli cell shape.
The biochemical tests in the present study were performed to elucidate the distinct metabolic activities produced from all the isolates administering a particular enzyme or biochemical activity thereby providing an insight into the ecology and physiology of the KSB isolates. Out of the 44 isolates, 27 isolates were detected to be positive for oxidase test, 33 isolates were found to be positive for catalase, 24 isolates were found to be positive for methyl red, 38 isolates were found to be positive for Voges–Proskauer test, 29 isolates were found to be positive for urease activity, and all the 44 isolates evinced citrate utilization and gelatin liquefaction activity (Supplementary Sheet Table S2). The results were in accordance with the studies conducted by Fatharani et al. [40], in which catalase test, Ziehl–Neelsen test, methyl red test, Voges–Proskauer test, urease test, nitrate reduction test, and citrate utilization test were performed to characterize potassium-solubilizing bacteria. All the seven isolates were reported to be positive for the catalase, Ziehl–Neelsen, and Methyl Red tests, six were positive for nitrate reduction and citrate utilization tests, two were positive for Voges–Proskauer test, and all were negative for urease test.
3.4. Molecular Characterization of KSB Using ARDRA, BOX, ERIC, and REP PCR
Alu I, Hae III, Hinf I, and Taq I provided distinctive and differentiating restriction patterns which were employed for the molecular characterization of all the isolates in the amplified ribosomal DNA restriction analysis (ARDRA; 16S rDNA PCR-RFLP technique). Using a 100 bp and 1 kb ladder as a molecular weight marker, the band patterns of the representative KSB strains are displayed in (Figure 2). Cluster analysis was utilized to examine genetic relationships using Jaccard’s similarity coefficient-based banding pattern. The dendrogram obtained from KSB strains differentiated the 44 strains into two major clusters with a coefficient ranging from 0.54 to 1.00. At coefficient 0.54, all the isolates were divided into two clusters, A and B. Cluster A comprised of total 35 KSB strains out of which KSB 7, 35; KSB 6, 30; KSB 42, 43 were found genetically similar at similarity coefficient 1.00. Cluster B comprised of 9 strains in which KSB 34, 35 were also found similar at similarity coefficient 1.00.

Figure 2.
(A) ARDRA pattern of 44 KSB strains using Hinf I. (B) Dendrogram based on ARDRA using UPGMA.
A similarity matrix was generated by comparing combined REP, BOX, and ERIC PCR in a pair-wise comparison pattern. Jaccard similarity indices established on the basis of 292 bands of combined primer (BOX, ERIC, REP) PCR ranged from 0.46 to 0.90 (Supplementary Figure S1). At coefficient 0.46, all the isolates were divided into two clusters, A and B. The first (A) cluster was divided into two sub clusters, A1 and A2. Sub-cluster A1 includes 27 strains KSB 1, KSB 24, KSB 8, KSB 9, KSB 13, KSB 25, KSB 2, KSB 4, KSB 16, KSB 14, KSB 17, KSB 15, KSB 3, KSB 11, KSB18, KSB 30, KSB 31, KSB 12, KSB 22, KSB 26, KSB 27, KSB 28, KSB 29, KSB 5, KSB 6, KSB 7, and KSB 10. Sub-cluster A2 comprises only four strains KSB 19, KSB 23, KSB 21, and KSB 30. Cluster 2nd (B) comprises a total of 13 strains and is further divided into two sub-clusters, B1 and B2. Sub-cluster B1 comprises eight strains KSB 32, KSB 33, KSB 34, KSB 35, KSB 36, KSB 37, KSB 39, and KSB 38. Sub-cluster B2 comprises four strains KSB 40. KSB 41, KSB 42, KSB 43, and KSB 44. The KSB isolates exhibited significant genetic diversity based on BOX, ERIC, and REP PCR profiles, and REP-PCR fingerprinting was found to be a highly reliable and reproducible approach in the current investigation to differentiate closely related bacterial strains. Recently, there have been significant advances in the characterization of microbial species brought about by the advent of more well-known molecular techniques, but there are still no simple ways to carry microbe identification all the way down to the strain level.
Similarly, Dong et al. [38] evaluated the identification of KSB isolates by 16SrDNA sequencing and on the basis of the similarity pattern classified into fourteen distinct ARDRA types. The isolates were clustered in four genera as Bacillus (A, B, C, E, F, G, and H); Enterobacter (I, J, K, and L); Pseudomonas (D and N); and Achromobacter (M). According to Jain et al. [32], the molecular diversity investigations using REP, ERIC, and BOX elements from repetitive DNA PCR revealed high genetic variation among the 30 zinc-tolerant bacteria. The study revealed that ERIC, REP, and BOX PCR profiles are highly reproducible and can easily distinguish between related bacterial species and ZTB isolates. It also revealed significant genetic divergence based on these profiles.
3.5. Determination of Physiological and PGPR Attributes of Potent KSB Strains
The major physiological attributes comprise temperature, salinity tolerance, pH, drought tolerance, and antibiotic sensitivity test. Potassium aids in activating various physiological and metabolic processes, thus enhancing the tissue water potentiality assisting in extreme temperature stress tolerance. The data indicated that the highest zone of solubilization was obtained at 30 °C, which was found to be the optimum temperature for growth of KSB isolates. It was further inferred that almost all the isolates showed significant solubilization in the temperature range of 30 °C to 50 °C. K solubilization increased at higher temperatures of incubation for all the bacterial strains as compared to that at low temperature range. A total of 41 strains were able to survive even at 50 °C with good KSI as compared to that at low temperatures, leading to an interpretation that the strains are more susceptible to high-temperature conditions (Supplementary Sheet Table S3). Verma et al. [17] conducted studies to ascertain the impact of the isolated bacteria grown on modified Aleksandrov broth at various temperatures ranging from 25 to 50 °C, demonstrating maximal solubilization (5.0 cm) at 25 °C and that it decreased with the rise in temperature. Other bacterial strains demonstrated substantial solubilization in the temperature range of 25 °C to 35 °C; however, bacterial strain UPS2C1 displayed maximum solubilization (4.13 cm) at 28 °C. All bacterial strains showed a decrease in K solubilization at a higher incubation temperature, i.e., 45 °C.
K plays an essential role in relation to the osmotic adjustment maintaining the turgor and regulating to all the metabolic activities under salinity stress. A range of varying concentrations (2–10%) of NaCl salt was added to the LB broth inoculated with the KSB isolates. Among the 44 isolates, 43 isolates were able to produce halo zones at 2%, 42 isolates at 4%, 39 isolates at 6%, and 12 isolates at 8%, whereas only 2 isolates were able to at 10% salt concentration. This clearly indicated that an increase in saline conditions inhibited the growth of the KSB strains (Supplementary Sheet Table S4). The growth potential of seven isolates was evaluated by Bachani et al. (2016) [41] in nutrient broth with varying NaCl concentrations from 0 to 20%, temperatures between 30 °C and 37 °C, and pH ranges from 3.0 to 8.0 and identified the halotolerant species as A. soli MTCC 5918, A. baumannii MTCC 5916, and E. xiangfangensis MTCC 5917.
To determine the effect of pH stress on K solubilization, all the 44 KSB isolates were grown under different pH conditions. Changes of pH in the medium were determined with a change in the pH of the LB broth medium from a range of pH 4–10. All the 44 KSB isolates exhibited growth at all the pH conditions. When bacterial isolates were grown in a medium with a pH of 6.0, it was discovered that K solubilization was at its highest. K solubilization decreased as the pH of the medium increased. At pH 6.0, strain KSB 13 showed the highest levels of K solubilization, followed by strain KSB 38 (Supplementary Sheet Table S5). Saha et al. [18] investigated the impact of pH variation on a subset of seven KSB strains. With the exception of Bacillus axarquiensis BHU27, Bacillus safensis BHU12 showed the greatest bacterial cell development at pH 8.0. This was followed by pH 7.2, and pH 8.6 (p140.05). It was discovered that pH 9.2 resulted in noticeably lower bacterial cell proliferation.
K also regulates turgor maintenance, osmotic adjustment, and aquaporin function under drought conditions. To check this, artificial drought conditions for all the 44 KSB isolates were recorded for 48 h and growth was measured on a spectrophotometer at 660 nm in comparison without PEG in Aleksandrov broth. All the 44 KSB isolates exhibited growth at 5–25% PEG concentration whereas only 7 isolates showed growth at 30% PEG concentration (Supplementary Sheet Table S6). Rodge et al. [42] assessed the capacity of rhizobacteria to boost plant growth in drought conditions and confirmed it in a plate test by providing water stress conditions. According to the findings, under conditions of water stress, rhizobacteria from Ficus religiosa dramatically increased root and shoot length compared to the controls.
An antibiotic sensitivity test was done by placing antibiotic discs of penicillin, ampicillin, neomycin, ceftizoxime, kanamycin, and tetracycline on the plates; the susceptibility or resistance of the bacterial strain towards a specific antibiotic was observed and the results are summarized in the table (Supplementary Sheet Table S7). Results were in accordance with the findings described by Karthik et al. [43], where the isolates were found to be sensitive to penicillin, gentamicin, neomycin, streptomycin, and vancomycin and resistant against ampicillin and methicillin. These findings led to the conclusion that antibiotic resistance helps the bacterial strain survive and adapt to harsh environmental circumstances during natural selection.
Plant growth-promoting rhizobacteria (PGPR) are a diverse group of soil bacteria that can solubilize potassium. They confer positive effects on the host plants in association, which stimulate the host plants’ growth through increased nutrient mobility, uptake, and enrichment through several mechanisms. As a result, they are vital for the preservation of soil ecology and fertility. Keeping all these benefits in consideration, all 44 KSB isolates were assessed for PGP attributes, i.e., phosphorus, zinc, silica, IAA, GA3, siderophore, ammonia production, GNFM, ACC deaminase, biofilm, antagonistic activity, EPS, and HCN production and the results are summarized in the table (Table 2 and Table 3).

Table 2.
Studies of PGPR attributes of KSB isolates.

Table 3.
Biochemical and plant growth-promoting attributes of KSB isolates.
All the 44 KSB isolates were found to be positive for ammonia production, GNFM test, and ACC deaminase test, whereas none of the isolates were reported to be positive for the formation of biofilm. A total of 26 isolates were found to be positive for HCN production whereas only 9 isolates exhibited antagonistic activity. In order to evaluate the P solubilizing potential, the 44 KSB isolates were spot inoculated on Pikovskaya medium agar plates and their solubilization indices were recorded. All the isolates were found positive with KSB 13 (3.95 ± 0.07) and KSB 35 (3.95 ± 0.07) exhibiting the maximum SI followed by KSB34 (3.85 ± 0.14). The minimum value was exhibited by KSB 8 (2.02 ± 0.06). Similarly, Aliyat et al. [44] demonstrated that the soluble phosphate in NBRIP medium ranged from 2.27 ≤ SPI ≤ 4.79, and the appearance of the halo zone in all strains was remarked after the third day of incubation.
Zinc in the plant depends on the total soluble Zn pool in the soil, with lower values resulting in reduced crop productivity and yield. Keeping this in view, KSB isolates were tested for their efficiency to solubilize zinc. KSB 38 (10.42 ± 0.13) showed maximum Zn solubilization followed by KSB 13 (10.40 ± 0.10) and KSB 39 (9.75 ± 0.13), whereas minimum by KSB 43 (3.77 ± 0.1). Similar studies were reported by Nagaraju et al. [45], in which the isolates were evaluated for their efficiency of zinc solubilization on TRIS minimal medium. Results revealed that the isolate ZnSF-4 showed a maximum solubilization zone of 54 mm and least solubilization zone was observed in ZnSB-8 (7 mm). All the isolates were tested on Bunt and Rovira media supplemented with 0.25% magnesium trisilicate and the silica solubilization index (SSI) was calculated. Out of the total 44 isolates, 33 isolates showed positive results. SSI was observed in KSB 41 (3.73 ± 0.12), followed by KSB 13 (3.25 ± 0.15), and KSB 38 (3.02 ± 0.12), whereas the minimum was observed in KSB 19 (2.02 ± 0.14). The capacity of the isolates to solubilize silicate, produce indole acetic acid (IAA), stimulate plant development, and induce silicon (Si) uptake in plants was examined by Kang et al. [46]. Based on its capacity to dissolve silica and the formation of IAA, a single bacterial isolate was selected.
Indole acetic acid (IAA) production is a major property of rhizospheric bacteria and stimulates and facilitates plant growth. The key precursor in the biosynthesis of IAA is tryptophan. All the KSB strains were tested for the qualitative and quantitative production of IAA. Maximum production was showed by KSB 41 (304.81 ± 0.79 µg/mL) followed by KSB 44 (260.77 ± 0.25 µg/mL) and KSB 13 (170.90 ± 0.15 µg/mL), whereas the minimum was showed by KSB 26 (11.12 ± 0.81 µg/mL). A total of 4 of the 63 KSB isolates tested by Shree et al. (2015) [47] were able to produce IAA. Between 0.229 and 0.458 ng/mL, all were positive for IAA production. Gibberellins are tetracyclic diterpenoid acids involved in a number of developmental and physiological processes in plants. Among all the tested 44 KSB isolates maximum GA3 was found in KSB 34 and minimum in KSB 37. Thirty fluorescent Pseudomonas sp. isolates were screened by Sharma et al. [48] from the rhizosphere of apple and pears, and their production of gibberellins was determined to be between 116.1 and 485.8 g/mL.
On treatment with Nessler’s reagent, all the 44 KSB isolates developed a brown to yellow color, indicating that all the isolates exhibited positive results. Shree et al. [47] concluded that all the isolates had the potential to produce ammonia, a PGPR trait that indirectly influences the growth of plants and microorganisms. The maximum ammonia production was observed in NKC-20 among all the isolates. The siderophore production efficacy of the 44 KSB isolates was observed using the chromo-azurol plate assay method. All the tested isolates were found to be positive, thus resulting in the formation of an orange halo zone around the colonies. KSB 41 (5.80 ± 0.10) followed by KSB 44 (5.55 ± 0.14) and KSB 34 (5.44 ± 0.13) showed the maximum zone of solubilization and KSB 42 (2.10 ± 0.20) exhibited the minimum value. Shree et al. [47] identified four out of 63 isolates and only 2 were found to be positive for siderophore production. Plant growth-promoting rhizobacteria (PGPR) with 1-aminocyclopropane-1-carboxylic acid (ACC) deaminase activity are the immediate precursor to the plant hormone ethylene and have the potential to support plant growth and development in unfavorable environmental conditions. In the present study, all the 44 KSB isolates evinced the ACC deaminase activity by their growth on minimal media containing ACC as the sole nitrogen source. Pashapour et al. [49] evaluated those 45 strains belonged to rhizobium and 2 bacterial strains belonged to Pseudomonas fluorescens. The results indicated that 15 strains produced ACC-deaminase.
The KSB isolates were grown on glucose nitrogen-free mineral agar (GNFM medium) and incubated for three to five days at 30 °C in order to assess their N2 fixing capacity. After the incubation period, the color of the medium changed from green to yellow, which was indicative of the isolates’ capacity to fix N2. All the isolates were found to be positive. As a potential alternative to reduce the effects of chemical fertilizer application, Akintokun et al. [50] evaluated the N2 fixing ability of the isolates as the first screening criterion. This trait is highly significant for plants. Total nitrogen fixation was present in 41 and 25% of the isolates from yellow and white maize, respectively. In order to study the antagonistic activity, inhibition tests with 44 KSB isolates against maize specific fungi were employed. A total of 9 KSB strains were found to exhibit antagonistic activity. According to Karthik et al. [43], strain AR6 exhibited high antagonistic activity against the plant pathogenic fungus A. niger. The ability of the rhizobacterial strain AR6 to produce protease, lipase, and amylase suggests that the most prominent characteristics of antagonism are the synthesis of hydrolytic enzymes.
The development of biofilms, in which bacterial cells adhere to abiotic and biotic surfaces, is a potential mechanism for mobilizing the K reserve in plants. In a biofilm, cells that are made up of polysaccharides, DNA, and junk proteins are immobilized inside a matrix of extracellular polymers that the cells themselves manufacture. In the current investigation, neither strain could cause the development of biofilms. In order to increase the amount of K released, Nagaraju et al. [45] screened the isolates for biofilm development. When biofilm is used, four hypho-bacteria have shown a high capacity for solubilizing potassium (K), which is discharged at a significantly high rate. Production of HCN plays a role in suppressing soil-borne pathogens and is therefore crucial for maintaining pathogen control. The picric acid assay was used to evaluate the effectiveness of potent KSB isolates. Out of the total 44 KSB isolates, only 26 isolates were found to be positive. Similar work was demonstrated by Rodge et al. [42] where only three isolates were found to be to be positive for HCN production, which acts as inducer of plant resistance; SMJ2II showed the fastest reaction in the picric acid assay. Exopolysaccharide (EPS) is a complex mixture of macro-molecular electrolytes found in the outer cells of bacteria that are discharged as mucus and that play a part in soil aggregation. It is characterized by the production of gummy secretions either around the colony periphery or by the entire colony in LB agar medium. All the 44 KSB isolates subjected to qualitative and quantitative estimation of exopolysaccharides were found to be positive. KSB 38 (2.16 ± 0.05 gm) exhibited the maximum value followed by KSB 44 (1.50 ± 0.09 gm) and KSB 43 (1.30 ± 0.01 gm), whereas the minimum value was showed by KSB 15 (0.05 ± 0.01 gm). Patel et al. [51] reported the extraction of EPS from a selected four isolates of the total nine isolates and recorded its dry weight. KPEP3 and KPEP4 exhibited the highest EPS production with 0.259 g and 0.312 g, respectively, from 100 mL culture broth.
Further, the hydrolytic enzymes were determined in 44 KSB strains and all the 44 KSB isolates were found to be positive for phytase [24], cellulase [52], amylase [53], and lipase [53]. Except for KSB 1, KSB 32, KSB 33, and KSB 43, all the 40 isolates showed a significant solubilization index for protease production (Table 4). Karthik et al. [43] isolated 48 different cultures, and all these isolates exhibited extracellular protease activity on skim-milk agar plates. Only 16 KSB isolates were found evincing the chitinolytic activity, whereas the rest were found negative, as no zone was observed on the chitin agar plates. Similar studies were reported by Kuzu et al. [54] including fifty-five strains from chitin wastes and which were tested for chitinolytic activity. After screening the strains for their ability to utilize chitin, 12 of them (2.18%) exhibited chitinolytic activity. Saiyad et al. [24] screened five phytase-positive bacteria on phytase screening turbid agar media plates; on the basis of zone of hydrolysis, the highest SI 3.13 was recorded for isolate B. coagulans II followed by B. isolate E. asburiaecoagulans I, Bu. Metallica, and B. megaterium. Sawangjit [52] evaluated eight cellulose-degrading bacteria from soil samples in the Samut Songkhram province, Thailand based on solubilization index. Geetha et al. [53] reported 140 bacteria from rhizospheric soils and the bacterial cultures were cultivated on nutrient agar medium supplemented with egg yolk. Overnight incubation of the cultures produced clear zones around the colony, indicating lipase activity. The strains KG-50 and TG-60 showed significant lipase activity.

Table 4.
Screening of isolates for determination of hydrolytic enzymes.
3.6. In Vitro Studies on the Effect of KSB on Growth of Maize Seedlings
Confirmation as well as substantiation of the KSB strains was done using the in vitro test in pots containing a sterile potting mixture; the results were summarized in Table 5. All the inoculated KSB strains performed better than the control. Out of 44 KSB strains only 5 strains, viz., KSB 13, KSB 34, KSB 38, KSB 41, and KSB 44, produced higher PGPR activities over other strains in plant growth parameters. Similar findings were made by Pande et al. [55] by recording the plant growth parameters after 20 days of germination. On the basis of the studies based on PGPR attributes and plant growth parameters, 10 efficient strains were selected amongst all the 44 KSB strains to study the effect of the stress related enzymes, viz., catalase (CAT), superoxide dismutase (SOD), peroxidase (POD), polyphenol oxidase (PPO), and phenylalanine ammonia lyase (PAL), in 30 day old maize seedlings (Table 6).

Table 5.
In vitro studies on the effect of KSB on growth of maize seedlings.

Table 6.
In vitro studies on the effect of KSB of various stress associated enzymes on maize seedling.
After 30 days of growth under in vitro conditions, the expression of stress-related enzymes, viz., catalase (CAT), superoxide dismutase (SOD), peroxidase (POD), polyphenol oxidase (PPO), and phenylalanine ammonia lyase (PAL) were significantly higher in the plantlet treated with selected KSB strains in comparison to the control plantlet (without KSB strain). The maize plantlet treated with KSB isolates exhibited the activity of SOD ranging from 0.21 ± 0.10 unit/mg fresh weight to 0.39 ± 0.10 unit/mg fresh weight in comparison to 0.18 ± 0.10 unit/mg fresh weight of uninoculated control. The highest activity of SOD was observed in the plantlets treated with KSB 13, whereas the lowest was in the case of KSB 21. Meanwhile, the activity of catalase was observed in the maize plantlet treated with KSB isolates which ranged from 1.38 ± 0.12 µmole/min/g to 3.20 ± 0.12 µmole/min/g, in comparison to 1.33 ± 0.08 µmole/min/g of uninoculated control. The highest activity of catalase was observed in the plantlets treated with KSB 13 whereas the lowest was in the case of KSB 31. The activity of PPO was recorded in the maize plantlet treated with KSB isolates which ranged from 0.015 ± 0.10 µmole/min/g to 0.018 ± 0.14 µmole/min/g in comparison to 0.014 ± 0.12 µmole/min/g of uninoculated control. The highest activity of PPO was observed in the plantlets treated with KSB 13 whereas the lowest was in the case of KSB 21 and KSB 35. Jain et al. [36] reported that an increase in superoxide dismutase, peroxidase, phenylalanine ammonia lyase, catalase, and polyphenol oxidase activity was observed on inoculation of ZTB strains. The activity of these enzymes was significantly lower in control plantlets (without Zn stress) as compared to the treated plantlets.
3.7. Sequencing and Phylogenetic Analysis of 16S rDNA of Potent KSB Strains
Based on the multiple PGP activities and in vitro efficiency studies on maize, four KSB trains were sequenced and analyzed for molecular identification and the results were presented in Figure 3; these sequences were submitted to NCBI and accession number was obtained and summarized in Table 7. Similar results were previously reported by Jain et al. [32,33,36].

Figure 3.
Phylogenetic analysis of potent KSB isolates based on 16S rDNA sequencing.

Table 7.
Molecular characterization of selected PGP potassium-solubilizing bacteria.
4. Conclusions
Thus, from the present study it can be inferred that KSB strains isolated from rhizospheric soil have the ability to solubilize the mineral K and can be used as potassium solubilizers; through their innate specialized mechanisms they can significantly contribute to enhanced plant growth and resistance to abiotic stresses. The use of these efficient indigenous strains as a microbial consortium could serve as an alternative to synthetic K fertilizers for maximal food production, thereby decreasing pollution and reclamation of degraded land for agricultural benefit.
Supplementary Materials
The following supporting information can be downloaded at: https://www.mdpi.com/article/10.3390/agronomy13071919/s1, Table S1: Morphological characteristics of isolated KSB; Table S2: Biochemical characterization of KSB isolates; Table S3: Temperature stress tolerance; Table S4: Salinity stress tolerance; Table S5: pH stress tolerance; Table S6: Drought stress tolerance; Table S7: Antibiotic sensitivity test; Figure S1: Amplification profiles of 44 KSB using (A) BOX, (B) ERIC and (C) REP PCR (D) Combined dendrogram of 44 KSB based on BOX, ERIC and REP PCR using UPGMA.
Author Contributions
Conceptualization, D.J.; methodology, H.S. and S.S.; software, S.K.U. and D.J.; validation, H.S., S.S. and D.J.; formal analysis, H.S., S.K.U., S.R.M. and D.J.; investigation, H.S. and S.S.; resources, D.J.; data curation, D.J.; writing—original draft preparation, H.S.; writing—review and editing, S.K.U., S.R.M. and D.J.; supervision, D.J. and S.R.M.; and funding acquisition, D.J. and S.R.M. All authors have read and agreed to the published version of the manuscript.
Funding
This research was funded by Maharana Pratap University of Agriculture and Technology Udaipur, India.
Data Availability Statement
The data presented in this study are available on request from the first author.
Acknowledgments
The authors are grateful to the Maharana Pratap University of Agriculture and Technology Udaipur, India for providing the resources for conducting the experiments. Devendra Jain gratefully acknowledges the financial support from IDP, NAHEP, ICAR, New Delhi for International training.
Conflicts of Interest
The authors declare no conflict of interest.
References
- Das, D.; Sahoo, J.; Raza, M.B.; Berman, M.; Das, R. Ongoing soil potassium depletion under intensive cropping in India and probable mitigation strategies: A review. Agron. Sustain. Dev. 2022, 42, 4. [Google Scholar] [CrossRef]
- Meena, V.S.; Maurya, B.R.; Verma, J.P.; Aeron, A.; Kumar, A.; Kim, K.; Bajpai, V.K. Potassium solubilizing rhizobacteria (KSR): Isolation, identification, and K-release dynamics from waste mica. Ecol. Eng. 2015, 81, 340–347. [Google Scholar] [CrossRef]
- Archana, D.S.; Nandish, M.S.; Savalagi, V.P.; Alagawadi, A.R. Characterization of potassium solubilizing bacteria (KSB) from rhizosphere soil. Bioinfolet 2013, 10, 248–257. [Google Scholar]
- Messaoudi, A.; Labdelli, F.; Rebouh, N.Y.; Djerbaoui, M.; Kucher, D.E.; Hadjout, S.; Ouaret, W.; Zakharova, O.A.; Latati, M. Investigating the Potassium Fertilization Effect on Morphological and Agrophysiological Indicators of Durum Wheat under Mediterranean Rain-Fed Conditions. Agriculture 2023, 13, 1142. [Google Scholar] [CrossRef]
- Sparks, D.L. Potassium dynamics in soils. Adv. Soil Sci. 1987, 6, 1–63. [Google Scholar]
- Meena, V.S.; Maurya, B.R.; Verma, J.P. Does a rhizospheric microorganism enhance K+ availability in agricultural soils? Microbiol. Res. 2014, 169, 337–347. [Google Scholar] [CrossRef]
- Xiao, Y.; Wang, X.; Chen, W.; Huang, Q. Isolation and identification of three potassium-solubilizing bacteria from rape rhizospheric soil and their effects on ryegrass. Geomicrobiol. J. 2017, 34, 873–880. [Google Scholar] [CrossRef]
- Sattar, A.; Naveed, M.; Ali, M.; Zahir, Z.A.; Nadeem, S.M.; Yaseen, M.; Meena, V.S.; Farooq, M.; Singh, R.; Rahman, M.; et al. Perspectives of potassium solubilizing microbes in sustainable food production system: A review. Appl. Soil Ecol. 2019, 133, 146–159. [Google Scholar] [CrossRef]
- He, B.; Xue, C.; Sun, Z.; Ji, Q.; Wei, J.; Ma, W. Effect of Different Long-Term Potassium Dosages on Crop Yield and Potassium Use Efficiency in the Maize–Wheat Rotation System. Agronomy 2022, 12, 2565. [Google Scholar] [CrossRef]
- Rengel, Z.; Damon, P.M. Crops and genotypes differ in efficiency of potassium uptake and use. Physiol. Plant. 2008, 133, 624–636. [Google Scholar] [CrossRef]
- Zhang, A.; Zhao, G.Y.; Gao, T.G.; Wang, W.; Li, J.; Zhang, S.-f.; Zhu, B.C. Solubilization of insoluble potassium and phosphate by Paenibacillus kribensis CX-7: A soil microorganism with biological control potential. Afr. J. Microbiol. Res. 2013, 7, 41–47. [Google Scholar]
- Kumar, A.; Patel, J.S.; Bahadur, I.; Meena, V.S. The molecular mechanisms of KSMs for enhancement of crop production under organic farming. In Potassium Solubilizing Microorganisms for Sustainable Agriculture; Meena, V.S., Maurya, B.R., Verma, J.P., Meena, R.S., Eds.; Springer: New Delhi, India, 2016; pp. 61–75. [Google Scholar]
- Meena, V.S.; Bahadur, I.; Maurya, B.R.; Kumar, A.; Meena, R.K.; Meena, S.K.; Verma, J.P. Potassium-solubilizing microorganism in evergreen agriculture: An overview. In Potassium Solubilizing Microorganisms for Sustainable Agriculture; Meena, V.S., Maurya, B.R., Verma, J.P., Meena, R.S., Eds.; Springer: New Delhi, India, 2016; pp. 1–20. [Google Scholar]
- Panday, S.C.; Choudhary, M.; Singh, S.; Meena, V.S.; Mahanta, D.; Yadav, R.P.; Pattanayak, A.; Bisht, J.K. Increasing farmer’s income and water use efficiency as affected by long-term fertilization under a rainfed and supplementary irrigation in a soybean-wheat cropping system of Indian mid-Himalaya. Field Crops Res. 2018, 219, 214–221. [Google Scholar] [CrossRef]
- Sindhu, S.S.; Parmar, P.; Phour, M. Nutrient cycling: Potassium solubilization by microorganisms and improvement of crop growth. In Geomicrobiology and Biogeochemistry; Springer: Berlin/Heidelberg, Germany, 2014; pp. 175–198. [Google Scholar]
- Mohamed, H.M.; El-Homosy, R.F.; Abd-Ellatef, A.H.; Salh, F.M.; Hussein, M.Y. Identification of yeast strains isolated from agricultural soils for releasing potassium bearing minerals. Geomicrobiol. J. 2017, 34, 261–266. [Google Scholar] [CrossRef]
- Verma, A.; Patidar, Y.; Vaishampayan, A. Isolation and purification of potassium solubilizing bacteria from different regions of India and its effect on crop’s yield. Indian J. Microbiol. Res. 2016, 3, 483–488. [Google Scholar]
- Saha, M.; Maurya, B.R.; Meena, V.S.; Bahadur, I.; Kumar, A. Identification and characterization of potassium solubilizing bacteria (KSB) from Indo-Gangetic plains of India. Biocatal. Agric. Biotechnol. 2016, 7, 202–209. [Google Scholar] [CrossRef]
- Parmar, P.; Sindhu, S. Potassium solubilization by rhizosphere bacteria: Influence of nutritional and environmental conditions. Res. J. Microbiol. 2013, 3, 25–31. [Google Scholar]
- Aleksandrov, V.G.; Blagodyr, R.N.; Ilev, I.P. Liberation of phosphoric acid from apatite by silicate bacteria. Microchem. J. 1967, 29, 111–114. [Google Scholar]
- Meena, V.S.; Maurya, B.R.; Meena, S.K.; Mishra, P.K.; Bisht, J.K.; Pattanayak, A. Potassium solubilization: Strategies to mitigate potassium deficiency in agricultural soils. Glob. J. Biol. Agric. Health Sci. 2018, 7, 3. [Google Scholar] [CrossRef]
- Parmar, K.B.; Mehta, B.P.; Kunt, M.D. Isolation, characterization and identification of potassium solubilization bacteria from rhizosphere soil of maize (Zea mays). Int. J. Sci. Environ. Technol. 2016, 5, 3030–3037. [Google Scholar]
- Edi-Premono, M.; Moawad, M.A.; Vleck, P.L.G. Effect of phosphate solubilizing Pseudomonas putida on the growth of maize and its survival in the rhizosphere. Indones. J. Agric. Sci. 1996, 11, 13–23. [Google Scholar]
- Saiyad, S.A.; Jhala, Y.K.; Vyas, R.V. Comparative efficiency of five potash and phosphate solubilizing bacteria and their key enzymes useful for enhancing and improvement of soil fertility. Int. J. Sci. Res. 2015, 5, 1–6. [Google Scholar]
- Hu, X.F.; Chen, J.; Guo, J.F. Two phosphate and potassium solubilizing bacteria isolated from Tiannu mountain, Zhejiang, China. World J. Microbiol. Biotechnol. 2006, 22, 983–990. [Google Scholar] [CrossRef]
- Jain, D.; Sharma, J.; Kaur, G.; Bhojiya, A.A.; Chauhan, S.; Sharma, V.; Suman, A.; Mohanty, S.R.; Maharjan, E. Phenetic and Molecular Diversity of Nitrogen Fixating Plant Growth Promoting Azotobacter Isolated from Semiarid Regions of India. BioMed Res. Int. 2021, 2021, 686283. [Google Scholar] [CrossRef]
- Reynolds, J. Lab Manual; Richland College; Springer: Berlin/Heidelberg, Germany, 2018; pp. 15–17. [Google Scholar]
- Schaad, N.W. Laboratory Guide for Identification of Plant Pathogenic Bacteria, 2nd ed.; International Book Distributing Co.: Lucknow, India, 1992; pp. 44–58. [Google Scholar]
- Vasisht, H.; Sharma, D.; Gupta, A. A Review on commonly used biochemical test for bacteria. Innovare J. Life Sci. 2013, 1, 1–7. [Google Scholar]
- Cappuccino, J.G.; Sherman, N. Biochemical Activities of Microorganisms Microbiology, a Laboratory Manual; The Benjamin/Cummings Publishing, Co.: San Francisco, CA, USA, 1992; pp. 105–130. [Google Scholar]
- Blazevic, D.J.; Ederer, G.M. Principles of Biochemical Tests in Diagnostic Microbiology; Wiley and Company: New York, NY, USA, 1975; pp. 13–45. [Google Scholar]
- Jain, D.; Sunda, S.; Sanadhya, S.; Nath, D.; Khandelwal, S. Molecular characterization and PCR based screening of cry genes from Bacillus thuringiensis strains. 3 Biotech 2017, 7, 1–8. [Google Scholar] [CrossRef]
- Jain, D.; Sanadhya, S.; Saheewala, H.; Maheshwari, D.; Sukhwal, A.; Singh, P.B.; Meena, R.H.; Choudhary, R.; Mohanty, S.R.; Singh, A. Molecular Diversity Analysis of Plant Growth Promoting Rhizobium Isolated from Groundnut and Evaluation of Their Field Efficacy. Curr. Microbiol. 2020, 77, 1550–1557. [Google Scholar] [CrossRef]
- Kour, R.; Jain, D.; Bhojiya, A.A.; Sukhwal, A.; Sanadhya, S.; Saheewala, H.; Jat, G.; Singh, A.; Mohanty, S.R. Zinc biosorption, biochemical and molecular characterization of plant growth-promoting zinc-tolerant bacteria. 3 Biotech 2019, 9, 1–17. [Google Scholar] [CrossRef]
- Rohlf, F.J. NTSYSpc Numerical Taxonomy and Multivariate Analysis System Version 2.0 User Guide; Applied Biostatistics Inc.: Setauket, NY, USA, 1998; p. 37. [Google Scholar]
- Jain, D.; Kour, R.; Bhojiya, A.A.; Meena, R.H.; Singh, A.; Mohanty, S.R.; Rajpurohit, D.; Ameta, K.D. Zinc tolerant plant growth promoting bacteria alleviates phytotoxic effects of zinc on maize through zinc immobilization. Sci. Rep. 2020, 10, 13865. [Google Scholar] [CrossRef]
- Bonugli-Santos, R.C.; Dos Santos Vasconcelos, M.R.; Passarini, M.R.; Vieira, G.A.; Lopes, V.C.; Mainardi, P.H.; Dos Santos, J.A.; de Azevedo Duarte, L.; Otero, I.V.; da Silva Yoshida, A.M.; et al. Marine-derived fungi: Diversity of enzymes and biotechnological applications. Front Microbiol. 2015, 6, 269. [Google Scholar] [CrossRef]
- Dong, X.; Lv, L.; Wang, W.; Liu, Y.; Yin, C.; Xu, Q.; Yan, H.; Fu, J.; Liu, X. Differences in distribution of potassium-solubilizing bacteria in forest and plantation soils in Myanmar. Int. J. Environ. Res. Public Health 2019, 16, 700. [Google Scholar] [CrossRef]
- Gore, N.S.; Navale, A.M. In vitro evaluation of potassium solubilizing potential of some rhizosphere Pseudomonas strains from Maharashtra, India. Int. J. Agric. Sci. 2019, 11, 8807–8811. [Google Scholar]
- Fatharani, R.; Rahayu, Y.S. Isolation and characterization of potassium solubilizing bacteria from paddy rhizosphere (Oryza sativa L.). J. Phys. 2018, 1108, 012105. [Google Scholar] [CrossRef]
- Bachani, P.; Bhattacharya, S.; Jain, D.; Patidar, S.K.; Soundarya, R.; Tirkey, S.R.; Ranawat, B.; Bharadwaj, S.V.V.; Mishra, S. Bioprospecting of Halotolerant Bacterial Isolates for Potassium Recovery from K-Feldspar. Chem. Eng. Technol. 2016, 39, 1645–1652. [Google Scholar] [CrossRef]
- Rodge, S.P.; Sable, S.K.; Salve, S.K.; Sawant, S.A.; Pati, N.P. Isolation and Characterization of PGPR from Roots of Ficus religiosa growing on Concrete Walls and its Effect on Plant Growth in Drought Condition. Int. J. Curr. Microbiol. App. Sci. 2016, 5, 583–593. [Google Scholar] [CrossRef]
- Karthik, C.; Oves, M.; Sathya, K.; Sri Ramkumar, V.; Arulselvi, P.I. Isolation and characterization of multi-potential Rhizobium strain ND2 and its plant growth-promoting activities under Cr (VI) stress. Arch. Agron. Soil Sci. 2017, 63, 1058–1069. [Google Scholar] [CrossRef]
- Aliyat, F.Z.; Maldani, M.; El Guilli, M.; Nassiri, L.; Ibijbijen, J. Isolation and Characterization of Phosphate Solubilizing Bacteria from Phosphate Solid Sludge of the Moroccan Phosphate Mines. Open Agric. 2020, 14, 16–24. [Google Scholar]
- Nagaraju, Y.; Triveni, S.; Subhashreddy, R.; Jhansi, P. Biofilm formation of zinc solubilizing, potassium releasing bacteria on the surface of fungi. Int. J. Curr. Microbiol. Appl. Sci. 2017, 6, 2037–2047. [Google Scholar]
- Kang, S.M.; Waqas, M.; Shahzad, R.; You, Y.H.; Asaf, S.; Khan, M.A. Isolation and characterization of a novel silicate-solubilizing bacterial strain Burkholderia eburnea CS4-2 that promotes growth of japonica rice (Oryza sativa L. cv. Dongjin). J. Soil Sci. Plant Nutr. 2017, 63, 233–241. [Google Scholar]
- Shree, N.; Kashyap, P.L.; Chakdar, H.; Srivastava, A.K.; Sharma, A.K. Isolation and characterization of potassium mobilizing bacteria from forest soils of Meghalaya. Indian J. Environ. Sci. 2015, 19, 43–48. [Google Scholar]
- Sharma, S.; Sharma, A.; Kaur, M. Extraction and evaluation of gibberellic acid from Pseudomonas sp.: Plant growth promoting rhizobacteria. J. Pharmacogn. Phytochem. 2018, 7, 2790–2795. [Google Scholar]
- Pashapour, S.; Besharati, H.; Rezazade, M.; Alimadadi, A.; Ebrahimi, N. Activity screening of plant growth promoting rhizobacteria isolated from alfalfa rhizosphere. Biol. J. Microbiol. 2016, 4, 16. [Google Scholar]
- Akintokun, A.K.; Ezaka, E.; Akintokun, P.O.; Shittu, O.B.; Taiwo, L.B. Isolation, screening and response of maize to plant growth promoting rhizobacteria inoculants. Sci. Agric. Bohem. 2019, 50, 181–190. [Google Scholar] [CrossRef]
- Patel, P.; Desai, B. Isolation, identification and production of lipase producing bacteria from oil contaminated soil. BMR Microbiol. 2018, 4, 1–7. [Google Scholar]
- Sawangjit, S. Isolation and characterization of cellulose-degrading bacteria from soils in Samut Songkhram province, Thailand. Int. J. Adv. Sci. Eng. Technol. 2017, 5, 2321–9009. [Google Scholar]
- Geetha, K.; Venkatesham, E.; Hindumathi, A.; Bhadraiah, B. Isolation, screening and characterization of plant growth promoting bacteria and their effect on Vigna radiata (L.) R. Wilczek. Int. J. Curr. Microbiol. Appl. Sci. 2014, 3, 799–809. [Google Scholar]
- Kuzu, S.B.; Guvenmez, H.K.; Denizci, A.A. Production of thermostable and alkaline chitinase by Bacillus thuringiensis subsp. Kurstaki strain-HBK-51. Biotechnol. Res. Int. 2012, 2012, 135498. [Google Scholar] [CrossRef]
- Pande, A.; Pande, P.; Mehra, S.; Singh, M. Phenotypic and genotypic characterization of phosphate solubilizing bacteria and their efficiency on the growth of maize. J. Genet. Eng. Biotechnol. 2017, 15, 2. [Google Scholar] [CrossRef]
Disclaimer/Publisher’s Note: The statements, opinions and data contained in all publications are solely those of the individual author(s) and contributor(s) and not of MDPI and/or the editor(s). MDPI and/or the editor(s) disclaim responsibility for any injury to people or property resulting from any ideas, methods, instructions or products referred to in the content. |
© 2023 by the authors. Licensee MDPI, Basel, Switzerland. This article is an open access article distributed under the terms and conditions of the Creative Commons Attribution (CC BY) license (https://creativecommons.org/licenses/by/4.0/).